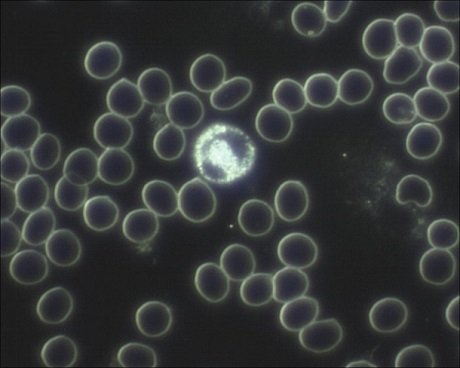

Erythrozyten-Werte: Verständlich erklärt
Die roten Blutkörperchen, auch Erythrozyten genannt, transportieren den lebenswichtigen Sauerstoff innerhalb der Blutgefäße, um ihn dann an die Zellen der Gewebe und Organe abzugeben. Das in großen Mengen in den Erythrozyten vorhandene Hämoglobin ist für die Bindung des Sauerstoffs verantwortlich.
Die roten Blutkörperchen reifen im Knochenmark und gelangen dann in die Blutbahn. Ihre Lebensdauer beträgt 120 Tage, deswegen müssen sie ständig neu gebildet werden. Die jungen Zellen (Retikulozyten) können im Blut von den ausgereiften Erythrozyten unterschieden werden. So kann auch die Neubildung der roten Blutkörperchen anhand der Retikulozytenwerte bestimmt werden.
|
Abb.1: Hier sehen Sie eine Aufnahme eines Bluttropfens unter dem Dunkelfeldmikroskop. Die zahlreichen runden „Scheiben“ sind die roten Blutkörperchen die hier völlig „normal“ erscheinen. Das größere helle Gebilde in der Mitte ist ein eosinohile Granulozyt, der zu den weißen Blutkörperchen gehört. Rechts in der Mitte sehen Sie einige Thrombozyten (Blutplättchen). Diese sehen wie kleine „Spinnennetze“ aus.
Die Zahl der Erythrozyten beim männlichen Gesunden beträgt 4,8 bis 5,9 Millionen pro µl (Mikroliter) Blut und bei Frauen 4,3 bis 5,2 Millionen/µl. Ist die Zahl der roten Blutkörperchen vermindert, so kommt es zu einer Sauerstoff-Unterversorgung der Organe. Man spricht dann von einer Anämie oder auch Blutarmut.
Die Ursachen können sehr unterschiedlich sein wie Erkrankungen der Nieren oder der Leber, Störungen des Hormon-Stoffwechsels, chronische entzündliche Prozesse, Tumore oder Vergiftungen mit Schwermetallen oder Medikamenten.
Auch durch starken Blutverlust, etwa nach Operationen, ist die Zahl der roten Blutkörperchen vermindert. Werden die roten Blutkörperchen zu schnell abgebaut (Hämolyse) so erkennt man dies an einem gesteigerten Wert des Abbauprodukts Bilirubin.
Anämien können aber auch durch zu geringe Kupfer, Eisen- oder Hämoglobinwerte im Blut entstehen und bei Vitmin B6 Mangel. Die Erythrozyten haben dann ein geringeres Volumen (mikrozytär) und sind schwächer rot gefärbt (hypochrom).
Auskunft über zu kleine oder zu große rote Blutkörperchen gibt das durchschnittliche Erythrozyten-Volumen oder MCV (Mean Corpuscular Volume). Der Normwert liegt bei 83 bis 97 fl (Femtoliter, 10-15 Liter). Zu große (makrozytäre) rote Blutkörperchen weisen auf Erkrankungen der Leber oder der Schilddrüse hin, können aber auch durch den Mangel an Folsäure oder Vitamin B12 verursacht werden. Möglich ist auch eine Verschiebung des Darm-Milieus in einen zu alkalischen Bereich.
Eine erhöhte Erythrozyten-Zahl (Polyglobulie) tritt bei Erkrankungen des Knochenmarks (Polycythaemia vera) auf oder bei Sauerstoffmangel, der durch verschiedene Grunderkrankungen bedingt ist.
Dies kann durch Lungenkrankheiten, aber auch durch Nierenkrankheiten und Herzkrankheiten hervorgerufen werden. Ebenso ist der Erythrozytenwert bei einem längeren Aufenthalt im Hochgebirge erhöht, da die Luft dort sauerstoffärmer ist. Aber auch eine Kohlenmonoxidvergiftung, vor allem bei starken Rauchern, kann als Ursache in Betracht gezogen werden. Andere Ursachen erhöhter Erythrozyten-Zahlen sind Tumore, Stoffwechselkrankheiten oder Hormonpräparate mit Testosteron, Cortison, Erythropoetin (Doping!).
Mit steigender Erythrozyten-Zahl nimmt der Anteil fester Blutbestandteile zu. Diesen Wert beschreibt der Hämatokrit, der bei Männern zwischen 40 % und 52 % und bei Frauen zwischen 37 % und 48 % liegt. Die hohe Bandbreite des Norm-Fensters spiegelt die je nach Quelle differierenden Angaben bzw. Meinungen.
Die Ursachen und Folgen eines erhöhten Hämatokrit sind ähnlich der der Erythrozyten-Zahl. Es kommt zu hoher Viskosität des Blutes und damit zu Belastungen des Kreislaufes. Herz-Probleme, Kopf- und Gelenkschmerzen, Schwindel und Juckreiz sind Symptome für einen erhöhten Hämatokrit.
Wichtig ist auch der Hämoglobin-Gehalt des Blutes. Diesen Parameter zeigt das durchschnittliche Hämoglobin-Gewicht eines roten Blutkörperchens an (Mean Corpuscular Hemoglobin, MCH). Der Normwert bewegt sich zwischen 28 und 33 Picogramm pro Zelle (pc, 10-12g/Zelle). Messwerte darunter bedeuten einen Hämoglobin-Mangel oder hypochrome Anämie. Ursache kann ein Defizit an Kupfer, Eisen oder Vitamin B6 sein. Zu hohe MCH-Werte zeigen eine hyperchrome Anämie an, dem meist ein Vitamin-B12- oder Folsäuremangel zugrunde liegt.
Eine andere Ausdrucksweise ist die Hämoglobin-Konzentration der festen Blutbestandteile (Mean Corpuscular Hemoglobin Concentration, MCHC). Beim Gesunden liegt der Wert bei 32 bis 36 g pro Deziliter (g/dl).
Bei der Sichelzellenanämie, einer Erbkrankheit, sind die Erythrozyten sichelartig verformt. Sie werden verstärkt abgebaut. Gleiches gilt für die verformten Erythrozyten der Kugelzellenanämie. Bei Thalassämien hingegen wird das Hämoglobin nicht in ausreichender Menge gebildet oder zu schnell abgebaut.
In der Schulmedizin werden Krankheiten isoliert betrachtet. Auch die Parameter rund um die einzelnen Blutbestandteile ordnet der konventionelle Arzt einem für sich bestehenden Krankheitsgeschehen hin.
In welcher Weise diese Anzeichen einer Störung im ganzen Menschen eingebettet sind, wird oftmals übersehen. Der Mensch ist eine Einheit aus Körper, Geist und Seele. Diese Teile bilden ein unauflösliches, ineinander verwobenes und wechselwirkendes System. Körperlich messbare Parameter reflektieren immer auch aktuelle und grundlegende psychologische Merkmale. Diese Zusammenhänge versucht die Regulations-Medizin nach Köhler/Lutz/Scholz und die 4-Farben-Theorie nach Lüscher zu beschreiben.
Max Lüscher folgend steht die Farbe Rot für Energie, Tatkraft und starkes Selbstbewusstsein. Ein geringer MCV-Wert, also zu kleine rote Blutkörperchen, sind demnach ein Indiz für eine insgesamt geschwächte Persönlichkeit. Das Selbstvertrauen ist zu „klein“, wie auch parallel dazu die Erythrozyten zu klein sind.
Die Verwirklichung der eigenen Ziele im Leben werden von diesen Patienten vernachlässigt. Die daraus resultierende Unzufriedenheit kann eine Suchterkrankung oder Depressionen zur Folge haben. Weitere Indizien für die gehemmte Aktivität dieser Menschen ist der gleichzeitig auftretende Mangel an Kupfer und Vitamin B6. Selbstverständlich sind die somatischen Symptome nicht zu vernachlässigen und eventuell eine Supplementierung mit den Vitalstoffen zu erwägen.
Bei zu hohem MCV, also zu großen roten Blutkörperchen, liegt eine verminderte Produktion neuer Erythrozyten vor. Die Parallele zu psychologischen Gegebenheiten ist in einer zu unflexiblen Handlungsweise zu sehen. Die Reaktion auf veränderte Verhältnisse fällt diesen Menschen schwer und sie können kaum die Initiative ergreifen, um neue Pläne zu verwirklichen. Sie behindern sich selbst, weil sie in alten Strukturen verharren. Hilfreich ist dann eine Supplementierung mit Vitamin B12 und eine Sanierung des zu alkalischen Darm-Milieus.
Lesen Sie auch den Artikel zu: Übersäuerung
Übrigens: Wenn Sie solche Informationen interessieren, dann fordern Sie unbedingt meinen kostenlosen Praxis-Newsletter „Unabhängig. Natürlich. Klare Kante.“ dazu an:
Beitragsbild: pixabay.com – qimono